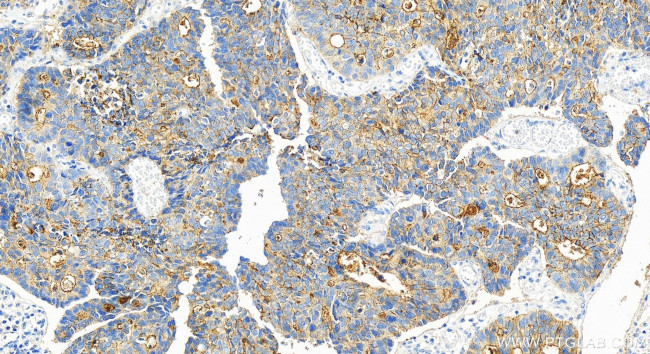
SLC7A2 Antibody in Immunohistochemistry (Paraffin) (IHC (P))

Search
Proteintech
SLC7A2 Polyclonal Antibody
{{$productOrderCtrl.translations['antibody.pdp.commerceCard.promotion.promotions']}}
{{$productOrderCtrl.translations['antibody.pdp.commerceCard.promotion.viewpromo']}}
{{$productOrderCtrl.translations['antibody.pdp.commerceCard.promotion.promocode']}}: {{promo.promoCode}} {{promo.promoTitle}} {{promo.promoDescription}}. {{$productOrderCtrl.translations['antibody.pdp.commerceCard.promotion.learnmore']}}
产品信息
30232-1-AP
种属反应
宿主/亚型
分类
类型
抗原
偶联物
形式
浓度
规格
纯化类型
保存液
内含物
保存条件
运输条件
产品详细信息
Immunogen sequence: ILVNIYLMVQ LSADTWVRFS IWMAIGFLIY FSYGIRHSLE GHLRDENNEE DAYPDNVHAA AEEKSAIQAN DHHPRNLSSP FIFHEKTSEF
靶标信息
The protein encoded by this gene is a cationic amino acid transporter and a member of the APC (amino acid-polyamine-organocation) family of transporters. The encoded membrane protein is responsible for the cellular uptake of arginine, lysine and ornithine. Three transcript variants encoding different isoforms have been found for this gene.
仅用于科研。不用于诊断过程。未经明确授权不得转售。
篇参考文献 (0)
生物信息学
蛋白别名: 20.5; amino acid transporter, cationic 2 (low affinity); CAT-2; Cationic amino acid transporter 2; cationic amino acid transporter 2A; cationic amino acid transporter 2B; cationic amino acid transporter-2A; Low affinity cationic amino acid transporter 2; solute carrier family 7 (cationic amino acid transporter, y+ system), member 2; Solute carrier family 7 member 2; solute carrier family 7, member 2; T-cell early activation protein; TEA
基因别名: 20.5; AI158848; ATRC2; CAT-2; CAT-2A; CAT-2B; CAT2; Cat2a; Cat2b; HCAT2; SLC7A2; SLC7A2A; SLC7A2B; Tea
UniProt ID: (Human) P52569, (Mouse) P18581, (Rat) B5D5N9
Entrez Gene ID: (Human) 6542, (Mouse) 11988, (Rat) 64554